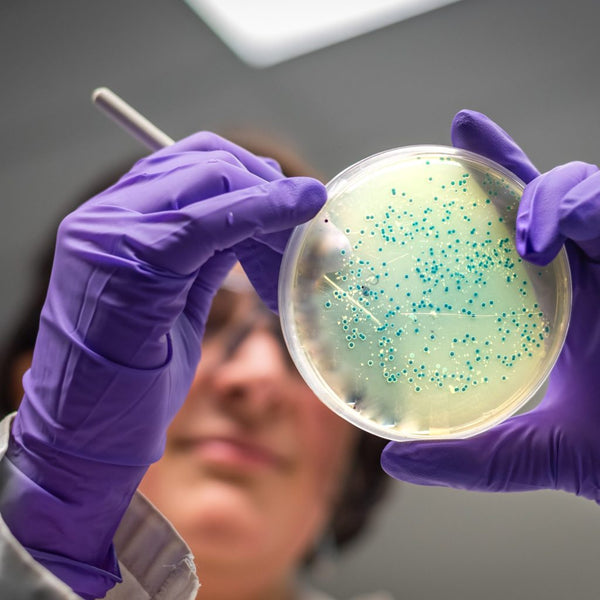

TECNOLOGÍA DE ESTRUCTURACIÓN
Explora los 4 pilares que devuelven al agua su coherencia natural
La Triple Coherencia: Energía, Estructura e Intención
PODER VIBRACIONAL
La botella Flaska resuena con entusiastas del bienestar que buscan algo más que la mera existencia. Se fundamenta en la capacidad del agua para recibir y almacenar energía, un principio que impacta positivamente en el bienestar físico y emocional.AGUA ESTRUCTURADA
El cristal de Flaska actúa como un sintonizador. Gracias a su programa vibracional único, el agua recupera su estructura natural en solo 5 minutos. Esta estructura es la que normalmente se puede observar en el agua de manantial, y se percibe a menudo como una mejora en el sabor y la textura. Así es como Flaska cumple su misión: elevar tu experiencia de hidratación.EL AGUA COMO VEHÍCULO DE INTENCIÓN
Flaska es una herramienta de coherencia. Al elegir beber agua estructurada, alineas conscientemente tu intención (mente) con tu biología (cuerpo). El agua, como matriz de la vida, es el vehículo perfecto para esa intención. Cada sorbo deja de ser un acto automático y se convierte en un gesto de autocuidado, profundizando la conexión mente-cuerpo-espíritu.
¿CÓMO FUNCIONA?
La canalización y distribución del agua hasta nuestras casas e incluso el embotellar el agua altera su estructura molecular hexagonal natural, volviéndola aleatoria y caótica.

El experimento de los Cristales de Agua del Dr. Masaru Emoto confirmó que el agua de la botella Flaska recupera su estructura en cinco minutos, formando armoniosos cristales hexagonales (copos de nieve). Esto indica que el programa vibracional de Flaska influencia positivamente la estructura del agua, un cambio que, como hemos visto, se percibe a menudo como una mejora en el sabor y la textura también.
EL DISEÑO
El diseño de Flaska es donde nuestra misión toma forma. No se trata solo de una apariencia atractiva; es una herramienta diseñada con un propósito.

Estructuración Vibracional del Agua
En el colegio aprendemos que el agua es H₂O. Inodora e insípida. Pero nuestra experiencia nos cuenta una historia muy diferente. El sabor del agua puede variar porque su estructura no es siempre la misma. El agua del grifo o la embotellada, tras un largo viaje, pierde su orden natural y se vuelve "caótica". En cambio, el agua de un manantial "el agua viva" fluye con una estructura organizada, sintiéndose fresca y suave.
Aquí es donde Flaska actúa.
Utilizamos nuestra tecnología 'Glass & Vibe' para imprimir en el cristal un programa vibracional formado por un conjunto de informaciones de frecuencias extraída de la naturaleza. Este "programa" permite que, en solo cinco minutos, la estructura del agua se reorganice y recupere su coherencia natural.
El Dr. Masaru Emoto lo plasmó visualmente. Sus famosas fotografías realizadas para nosotros muestran la diferencia: los Cristales de Agua de Flaska forman copos armoniosos, con la estructura hexagonal perfecta que se encuentra en la naturaleza, mientras que los del agua del grifo son caóticos.